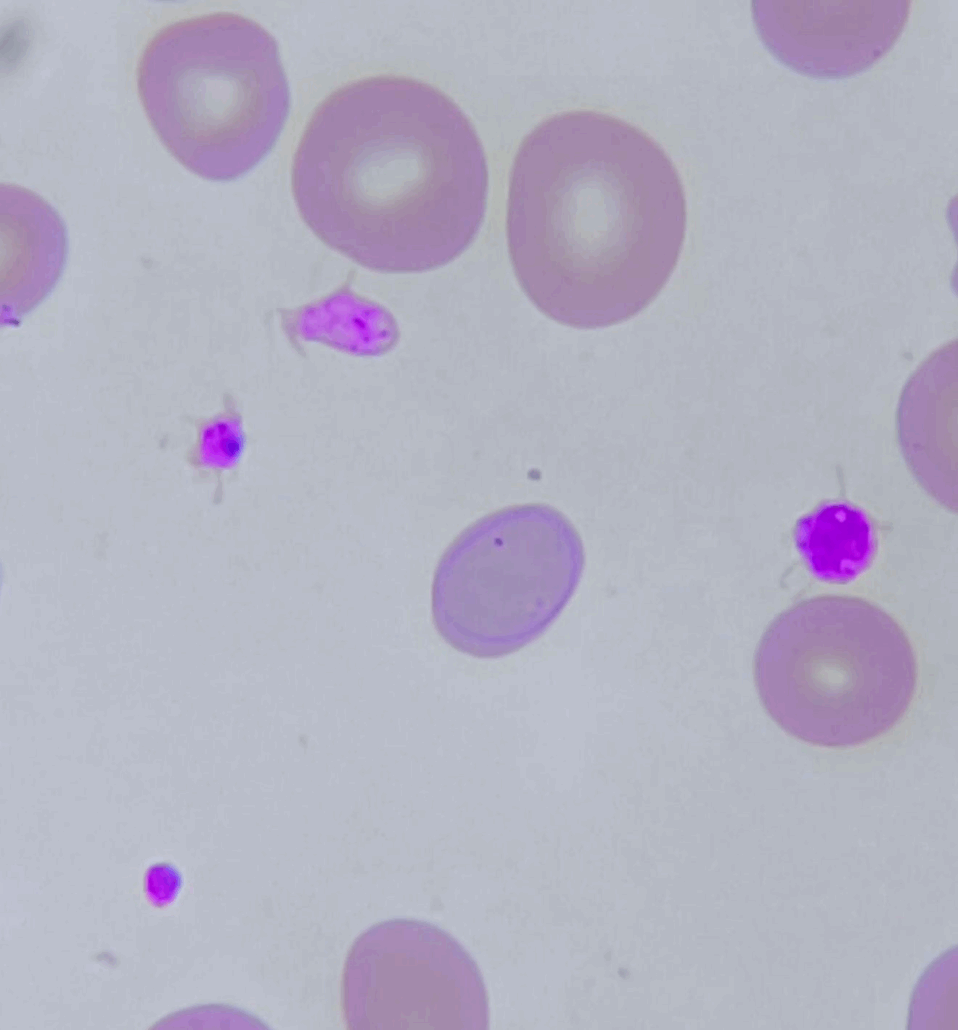

O Anel de Cabot é uma inclusão eritrocitária rara, visualizada em esfregaços de sangue periférico. Geralmente, está associado a distúrbios na eritropoese e na maturação nuclear dos eritrócitos. Nesse contexto, sua presença funciona como um indicativo indireto de anormalidades na síntese de hemoglobina ou de defeitos na maturação nuclear. Por isso, o anel de cabot é um achado morfológico relevante para o diagnóstico diferencial de anemias e outras condições hematológicas.
Características Morfológicas
- Forma: Estruturas anelares, geralmente em forma de laço ou oito, localizadas dentro do citoplasma do eritrócito.
- Cor: Basofílica, sendo visível em colorações usuais, como Wright, Giemsa ou May-Grünwald-Giemsa.
- Localização: Dispostas no interior da hemácia, sem, contudo, manter relação direta com a membrana celular.
- Estrutura: Compostas por restos de microtúbulos do fuso mitótico ou, alternativamente, por fragmentos de cromatina nuclear.
Anel de Cabot presente no interior da hemácia
Mecanismo de Formação
O anel de Cabot está intimamente relacionado a desordens na divisão nuclear durante a eritropoese, o que resulta na persistência de estruturas nucleares anormais.
- Eritropoese ineficaz: Ocorre quando a maturação do núcleo e do citoplasma está dessincronizada, levando assim à formação dessas inclusões.
- Defeitos megaloblásticos: A deficiência de vitamina B12 ou ácido fólico compromete a mitose nuclear, favorecendo, dessa forma, o aparecimento do anel de Cabot.
- Resíduos mitóticos: Representam estruturas do fuso mitótico que não foram adequadamente degradadas, persistindo no interior da célula.
Condições Associadas
Embora a presença do anel de Cabot não seja específica, ela está frequentemente associada a diversas patologias hematológicas. Entre as principais, destacam-se:
- Anemias megaloblásticas (devido à deficiência de B12 ou folato)
- Anemia perniciosa
- Anemia hemolítica grave
- Leucemias e síndromes mielodisplásicas
- Pós-esplenectomia
- Saturnismo (intoxicação por chumbo)
Portanto, sua ocorrência deve ser interpretada com base no contexto clínico do paciente.
Importância Diagnóstica
O achado de anéis de Cabot no esfregaço sanguíneo é considerado um marcador de diseritropoese. Dessa maneira, deve sempre motivar a investigação da causa subjacente.
- Em anemias megaloblásticas, esses anéis podem coexistir com macrocitose, hipersegmentação de neutrófilos e pontilhado basofílico, reforçando assim o diagnóstico.
Nas mielodisplasias, costumam estar associados a poiquilocitose e anisocitose acentuadas, o que amplia a complexidade morfológica do quadro.

Referências:
- Bain BJ. Blood Cells: A Practical Guide. 5th ed. Wiley-Blackwell; 2015.
- Hoffbrand AV, Moss PAH. Essential Haematology. 7th ed. Wiley-Blackwell; 2016.
- Wintrobe MM. Wintrobe’s Clinical Hematology. 14th ed. Wolters Kluwer; 2018.

